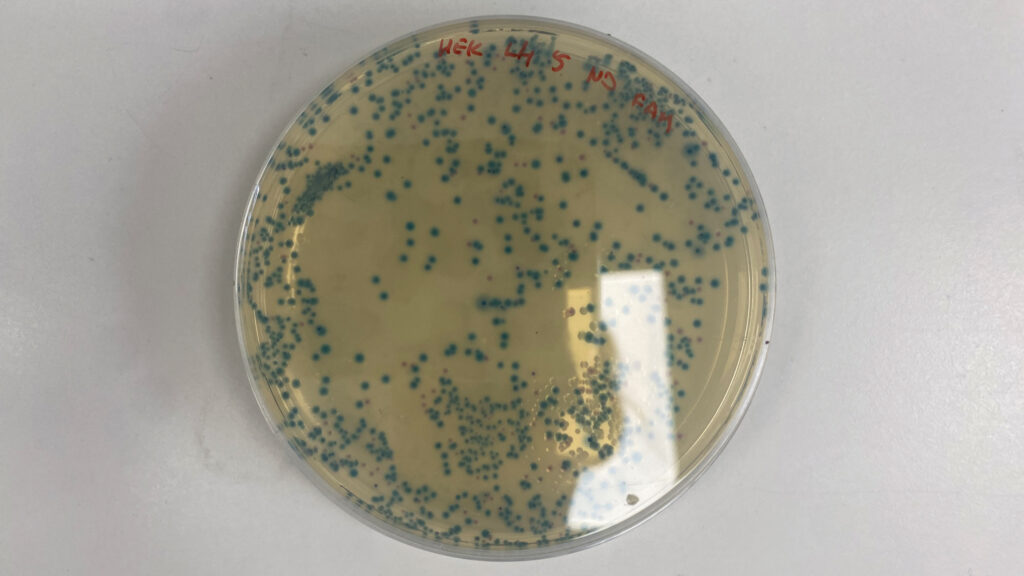

Advice on disinfection of livestock trailers

Washing hands and wearing gloves while cleaning and disinfecting livestock trailers can help to reduce the spread of zoonotic pathogens as well as antimicrobial-resistant bacteria.
Following government guidelines for cleaning and disinfecting stock trailers is effective at reducing bacteria numbers – even if it cannot sterilise vehicles and eliminate all bacteria, says microbiologist Dr Joanna Urbaniec of the Livestock and One Health Department of the University of Liverpool.
See also: How lung washing slashed antibiotics use in calf shed
Global predictions that within 30 years, most antibiotics will no longer work – in either humans or animals – have put pressure on agriculture to control antimicrobial-resistant (AMR) strains of bacteria, says Joanna.
Furthermore, a 2022 report by the European Food Safety Authority concluded it was “almost certain” that livestock transport contributed to the spread of antibiotics resistance.
Cleaning protocols
As thousands of private and commercial journeys are made every month, transporting livestock between holdings, to slaughter or to market, Joanna says there is potential to spread pathogens among multiple holdigns – and into the food chain.
“Livestock trailers can harbour zoonotic pathogens with AMR properties, and it’s possible that if cleaning and disinfecting fail to eradicate bacteria, then transport vehicles can help spread these pathogens,” she explains.
“If you walk in and out of a trailer that is not very clean, you are at big risk of spreading pathogens and AMR from one farm to another.”
Unfortunately, government advice to clean and disinfect vehicles within 24 hours of unloading (or before they are used again, whichever is sooner) is not enforced at markets, she points out.
But she says farmers can ensure due diligence in sticking to cleaning protocols at home, as this is an important step in reducing bacterial load.
However, it is important to note that the process is hampered by weather and bedding material.
Ambient temperatures affect bacteria survival in a trailer, while rain will alter disinfectant contact time and drying.
Similarly, straw is the preferred bedding in livestock transport, to prevent faeces leaking onto the road when travelling, yet it makes it harder to clean the nooks and crannies in vehicles, says Joanna.
“So, take care of your personal biosecurity – dip and scrub your boots, wash your hands, wear gloves when cleaning, and clean your trailer as well as you can,” is her advice.
“Even just pressure washing reduces contamination: many disinfectants don’t work if they are mixed with organic matter.
“Because cleaning reduces the number of bacteria in a trailer, it means you are less likely to pick them up on your boots.”
Livestock trailer E coli study highlights AMR risk
© Joanna Urbaniec
Dr Joanna Urbaniec carried out a pilot study involved monitoring E coli levels in trailers used for transporting batches of calves from dairy farms to the University of Liverpool farm for a pneumonia trial (see “Testing livestock trailers for E coli”).
Her aim was to determine if, and where, this common bacteria persists in vehicles, then survey the levels of antibiotic resistance of recovered E coli isolates (isolated micro-organisms).
She explains that E coli is mostly harmless (though some types are pathogenic and can kill) and susceptible to antibiotics and disinfectants, although resistance to both can easily be acquired.
Risk of resistance to disinfectants
Parts of DNA known as plasmids circulate within the bacteria and the environment. They contain genes resistant to antimicrobials and/or disinfectants.
“When bacteria cells leak or burst and release plasmids, they can be picked up by other bacteria, and this is how AMR can be spread,” Joanna explains.
She says bacteria can develop resistance to disinfectants through overuse or improper techniques.
“Not measuring disinfectant properly – such as splashing it in, or a glug – means that the concentration is lower than recommended. Or it is left too long without being changed for fresh and is contaminated by organic matter [which stops it working].”
Her study showed that, given a typically dirty livestock trailer would contain millions of colony-forming units (cfu) of E coli, bacteria numbers were drastically reduced after cleaning and disinfection.
“After cleaning, we found 100cfu in an area 10x5cm on the side of the trailer; after disinfecting with FAM30 [multipurpose agricultural disinfectant], the majority of swabs had zero cfu.”
She adds that the most contaminated places were underneath the side railing and on the trailer ramp.
Multidrug resistance
Joanna found high levels of resistance to tetracyclines, beta-lactams and sulphonamides, regardless of disinfection.
She says 40% of screened isolates were also classified as multidrug-resistant (resistant to at least one antibiotic from three or more classes of antibiotics).
“So, to reduce AMR, we will need to [continue to] reduce antibiotics use on farm: reducing antibiotics in the cow is the most effective way, with good biosecurity protocols to prevent spreading from cow to calf.”
Testing livestock trailers for E coli

© Joe Neary
Livestock
- 120 dairy-beef calves
- Four to 12 calves in each trailer load
- Calves split 50:50 male and female
- Aged 10 weeks
- Weights ranged from 60kg to 100kg
- Calves collected in three batches (May, October and February) to reflect changes in weather
Transport
- Three different trailers used: one from a farm vet practice so not used very often; a regular farm trailer; and one used for one farm plus transport to auction
- Trailers cleaned before collecting calves
- Journey times 30 minutes to three hours
- No bedding in the trailer to keep it clean
Disinfection
- Trailers pressure washed to remove visible dirt within 20 minutes of unloading
- Sprayed with FAM30, contact time of 30 minutes
- Rinsed and left to dry
*Following the Transport of Animals (Cleansing and Disinfection) (England) (No 2) Order 2000
Tests
- Swabs taken from five sites (pre and post disinfection) in the trailers
- Swabs cultured for E coli in 24 hours
- 29 selected E coli isolates surveyed for antibiotics resistance
Calf data
- Colostrum records
- Blood test results for passive transfer
- Disease treatment history
- On arrival: calves measured for temperature, signs of illness and scour, lung lesions
Source: Dr Joanna Urbaniec